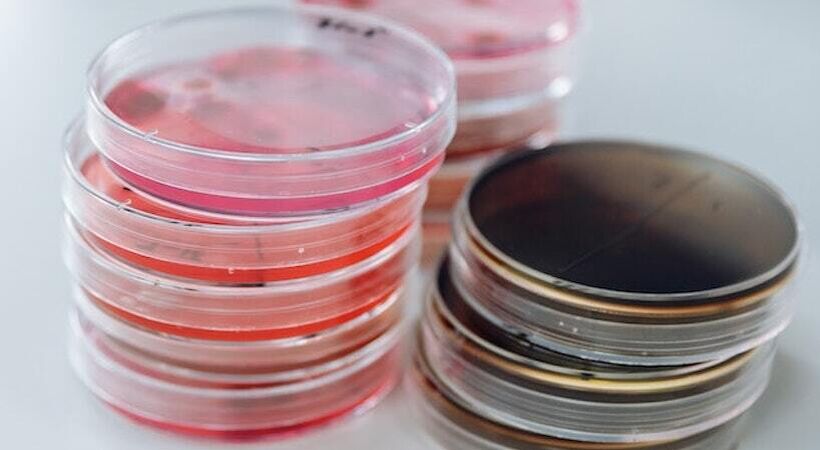
Cleaning&Maintenance tweet media

Don't miss Erum Ahmed Sales Director, and John Lear, Technical Director sharing their expertise and valuable insights on the latest advancements in the cleaning industry at @intercleanshow. Register for your FREE ticket here 👉🏻: bit.ly/4cOvXFb

English